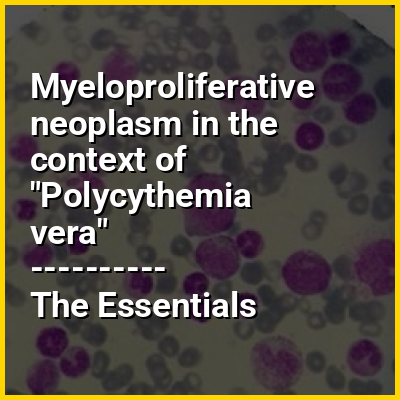

Myeloproliferative neoplasms (MPNs) are a group of rare blood cancers in which excess red blood cells, white blood cells or platelets are produced in the bone marrow. Myelo refers to the bone marrow, proliferative describes the rapid growth of blood cells and neoplasm describes that growth as abnormal and uncontrolled.
The overproduction of blood cells is often associated with a somatic mutation, for example in the JAK2, CALR, TET2, and MPL gene markers.